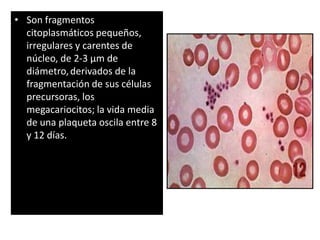
• Son fragmentos
citoplasmáticos pequeños,
irregulares y carentes de
núcleo, de 2-3 µm de
diámetro, derivados de la
fragmentación de sus células
precursoras, los
megacariocitos; la vida media
de una plaqueta oscila entre 8
y 12 días.

Incrustar presentación
Descargado 47 veces








Las plaquetas son fragmentos citoplasmáticos pequeños derivados de las células precursoras megacariocitos que circulan en la sangre de los mamíferos. Juegan un papel fundamental en la hemostasia iniciando la formación de coágulos, y liberan factores de crecimiento como el PDGF y TGF-beta que estimulan la regeneración y reparación del tejido conectivo. Cualquier anormalidad en el número o función de las plaquetas se denomina trombocitopatía.